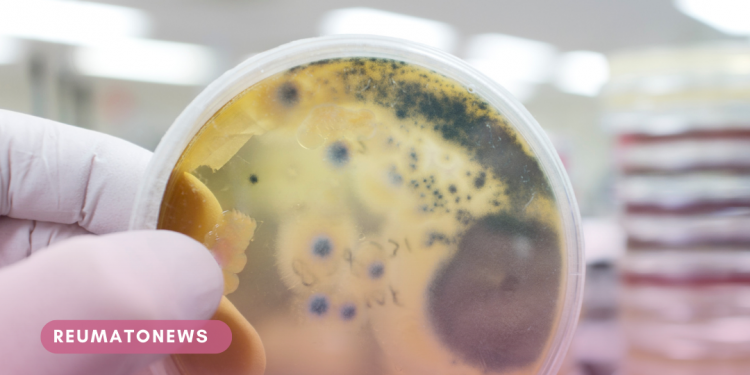
OMS divulga lista inédita com fungos mais perigosos para a saúde

A Organização Mundial da Saúde (OMS) divulgou, pela primeira vez, um relatório com os 19 fungos que mais ameaçam a saúde pública. Na lista, estão os patógenos fúngicos que ameaçam pacientes com câncer, transplantados e que vivem com o HIV.
O objetivo da entidade é estimular um esforço global em pesquisa e respostas para infecções, bem como para o problema da resistência a antifúngicos. A relevância do relatório está associada às tentativas de diminuir o risco que os patógenos fúngicos oferecem a pacientes imunossuprimidos.
Segundo a OMS, os fungos estão cada vez mais comuns. Além disso, esses patógenos têm se tornado resistentes aos tratamentos, que são escassos.
Atualmente, há apenas quatro classes de medicamentos antifúngicos disponíveis. Outro gargalo diz respeito ao diagnóstico das infecções, uma vez que as opções de testes rápidos e sensíveis são restritas e não são acessíveis em todo o mundo.
Entre os fungos classificados como de prioridade crítica pela entidade, estão o Candida albicans, causador da candidíase oral e vaginal, e o Candida auris, também chamado de superfungo por ter potencial letal e capacidade de se alastrar em ambientes hospitalares.
A candidíase vaginal, por exemplo, é bastante comum. Uma pesquisa feita pelo Ibope e encomendada pela farmacêutica Bayer mostrou que 52% das mulheres brasileiras já tiveram candidíase ao menos uma vez na vida. Já a Candida auris infectou 18 pessoas durante a pandemia de Covid-19 no Brasil, aponta a Anvisa. Ao todo, foram três diferentes surtos de contaminação.
Importância da lista
O relatório foca em certos tipos de pacientes, pois os fungos ameaçam principalmente aqueles que têm fragilidades no sistema imunológico, como pacientes com câncer, que vivem com o HIV, transplantados e pessoas com doenças respiratórias crônicas.
“Emergindo das sombras da pandemia de resistência antimicrobiana bacteriana, as infecções fúngicas estão crescendo e são cada vez mais resistentes aos tratamentos, tornando-se uma preocupação de saúde pública em todo o mundo” , disse, em comunicado, Hanan Balkhy, diretor-geral assistente da OMS para resistência antimicrobiana (AMR).
Fonte: Assessoria de Imprensa
Descubra mais sobre Artrite Reumatóide
Assine para receber nossas notícias mais recentes por e-mail.